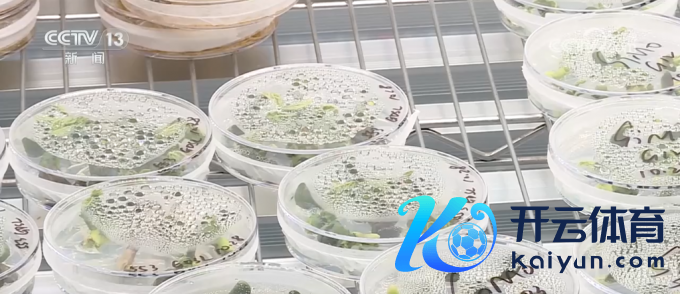

你的位置:开云·kaiyun体育(中国)官方网站 登录入口 > 新闻 > 体育游戏app平台在四川邛崃天府当代种业园-开云·kaiyun体育(中国)官方网站 登录入口
体育游戏app平台在四川邛崃天府当代种业园-开云·kaiyun体育(中国)官方网站 登录入口
时间:2025-12-21 21:15 点击:88 次

本年,中国农业发展银行加大种业战略性金融相沿力度,要点相沿国度级育制种基地、区域性良种繁育基地、制种大县等配置,收场四大国度级育制种基地信贷资金全遮掩。收尾11月15日,中国农业发展银行本年累计投放种业贷款总和达到284亿元。

在四川邛崃天府当代种业园,这里的15亩历练田正在播撒油菜新品种。
天府当代种业园是我国西南地区唯独的国度级农作物种业产业园,农刊行四川省分行先期贷款1.2亿元,用于园区的施行室和种业尺度化厂房等基础才智配置。

中国农业发展银行四川省分行副行长龚晋暗示,本年,银行共投放种业贷款8亿元,贷款余额28亿元,收场对四川省省内国度级制种、育种基地收场了全遮掩相沿。

在黑龙江,针对大豆育种企业种子繁育历程长、研发参预大、资金盘活慢的特色,农刊行黑龙江省分行罗致“农业科技短期流动资金贷款+中长久技俩贷款”方法,为国内种业领军企业北大荒垦丰种业公司量身定制组合融资决策,本年已累计向该企业授信8.79亿元,投放贷款2.92亿元,灵验处理了育种基地技俩配置和推敲地流动资金一揽子融资需求。当今,分手位于海南、甘肃、四川、黑龙江的我国四大国度级育制种基地配置已统共赢得农刊行信贷资金相沿。收尾11月15日,农刊行累计投放种业贷款总和达到284亿元。
体育游戏app平台
体育游戏app平台


